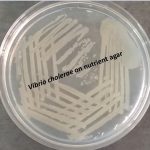
Vibrio cholerae on nutrient agar
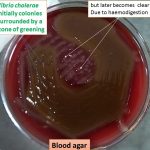
Vibrio cholerae on blood agar
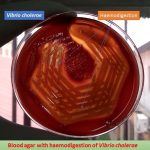
Vibrio cholera on blood agar showing haemodigestion

Collection Group: Clinical Bacteriology
Vibrio cholerae on nutrient agar and Its Details
Vibrio cholerae on nutrient agar Vibrio cholerae on nutrient agar...
Vibrio cholerae on nutrient agar Vibrio cholerae on nutrient agar...
Vibrio cholerae on Blood Agar and Its Details
Vibrio cholerae on Blood Agar Vibrio cholerae on blood agar...
Vibrio cholerae on Blood Agar Vibrio cholerae on blood agar...
Vibrio cholerae on Blood Agar Showing Haemodigestion and Vibrio cholerae Details
Vibrio cholerae on Blood Agar Showing Haemodigestion Vibrio cholerae on...
Vibrio cholerae on Blood Agar Showing Haemodigestion Vibrio cholerae on...
